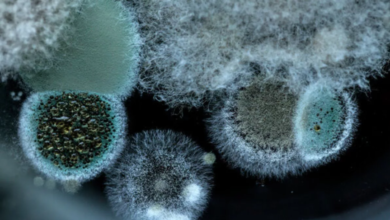
Photo of Covid-19 के बाद Black Fungus ने बढ़ाई चिंता, ICMR की रिपोर्ट ने चौंकाया; आख‍िर क्‍या है ये बीमारी?

भागदौड़ भरी जिंदगी और तेजी से बदलती लाइफस्टाइल इन दिनों लोगों को शारीरिक और मानसिक रूप से थका रही है। हमारे आसपास कई लोग लगातार विभिन्न समस्याओं का शिकार होते जा रहे हैं। काम का बढ़ता प्रेशर और हमारी कुछ आदतें तेजी से हमारी मानसिक सेहत को प्रभावित कर रही है। इन दिनों कई लोग तनाव का शिकार होते जा रहे हैं। तनाव कई तरह से हमारे शरीर पर असर डालता है, जिसके बारे में शायद की आप जानते होंगे।
यूं तो तनाव हमारी सेहत के लिए हानिकारक है ही, लेकिन आज इस आर्टिकल में हम आपको विस्तार से बताएंगे कि कैसे तनाव आपके शरीर और आपके विभिन्न बॉडी पार्ट्स को प्रभावित करता है। आइए जानते हैं-
दिल
लंबे समय तक तनाव ब्लड प्रेशर और हार्ट रेट को बढ़ा सकता है, जिससे हाई ब्लड प्रेशर, दिल के दौरे और स्ट्रोक जैसी दिल से जुड़ी बीमारियों का खतरा बढ़ सकता है। जॉन्स हॉपकिन्स मेडिसिन के मुताबित, तनाव के कारण हार्ट रेट तेज हो सकती है, जिसे टैचीकार्डिया कहा जाता है। टैचीकार्डिया सामान्य हार्ट फंक्शन में बाधा डाल सकता है और अचानक कार्डियक अरेस्ट का खतरा बढ़ सकता है। इसके अलावा कभी-कभी तनाव ज्यादा खाने या धूम्रपान जैसी अनहेल्दी आदतों को भी बढ़ावा देता है, जिससे दिल पर और बुरा असर पड़ता है।
दिमाग
अगर आप बहुत ज्यादा तनाव लेते हैं, जो इससे आपके दिमाग पर असर पड़ता है और आपकी याद्दाश्त धुंधली हो सकती है। दरअसल, तनाव कोर्टिसोल जैसे हार्मोन को ट्रिगर करता है। यह एक स्ट्रेस हार्मोन है, जो हमारे कॉग्नेटिव फंक्शन को खराब कर सकता है, जिससे फोकस करने में कठिनाई होती है और निर्णय लेने में मुश्किल होती है।
पेट और पाचन तंत्र
जब आप तनाव लेते हैं, तो आपको कई घबराहट होने लगती है या पेट में दर्द महसूस होता है। ऐसा इसलिए क्योंकि पेट का तनाव से भी संबंध है। अगर आप बहुत ज्यादा तनाव लेते हैं, तो आपके शरीर को ठीक होने में कठिनाई होगी। इससे पाचन क्रिया बाधित होती है और पेट खराब हो सकता है। तनाव की वजह से आपको पेट खराब होना, दस्त, कब्ज और इरिटेबल बाउल सिंड्रोम जैसी गैस्ट्रोइंटेस्टाइनल समस्याएं हो सकती हैं।
मांसपेशियां
अगर आप अक्सर अपनी गर्दन, कंधे और पीठ में अकड़न महसूस करते हैं और आपको इसका कारण समझ नहीं आ रहा है, तो यह लगातार बैठे रहने और खराब पोइश्चर के अलावा तनाव भी हो सकता है। गर्दन, कंधों और पीठ में मसल्स टेंशन और दर्द तनाव का दुष्प्रभाव हो सकता है।
त्वचा
तनाव का असर आपकी त्वचा पर भी दिखता है। ज्यादा तनाव लेने से मुंहासे, एक्जिमा, सोरायसिस और रोसैसिया जैसी त्वचा संबंधी समस्याएं हो सकती है। साथ ही इसकी वजह से त्वचा की हीलिंग प्रोसेस भी धीमी सकती है, जिससे घाव ठीक होने में देरी हो सकती है और मौजूदा त्वचा संबंधी समस्याएं बढ़ सकती हैं।
इम्यून सिस्टम
लगातार तनाव आपके इम्यून सिस्टम को कमजोर कर देता है, जिससे व्यक्ति इन्फेक्शन, बीमारियों और ऑटोइम्यून बीमारियों के प्रति ज्यादा संवेदनशील हो जाता है। स्ट्रेस हार्मोन इम्यून रिएक्शन्स को कमजोर कर सकता है, जिससे आपके शरीर की कीटाणुओं से लड़ने की क्षमता खराब हो सकती है।
आंखें
तनाव आपकी आंखों को भी प्रभावित करता है। इसकी वजह से आंखों में सूजन, ब्लर विजन, आंखें फड़कना और सिरदर्द जैसी समस्याएं हो सकती हैं। इसके अलावा लंबे समय तक तनाव ग्लूकोमा जैसी स्थितियों को बढ़ा सकता है या समय के साथ विजन संबंधी समस्याओं के विकास में योगदान कर सकता है।
रिप्रोडक्टिव सिस्टम
स्ट्रेस हार्मोन, कोर्टिसोल, पुरुषों और महिलाओं दोनों के रिप्रोडक्टिव फंक्शन को प्रभावित करता है। इससे शारीरिक संबंध बनाने की इच्छा में कमी, पीरियड्स में अनियमितता समेत अन्य फर्टिलिटी संबंधी समस्याएं हो सकती हैं। लंबे समय तक तनाव प्रेग्नेंसी को भी प्रभावित कर सकता है और समय से पहले जन्म या जन्म के समय कम वजन जैसी जटिलताओं में योगदान कर सकता है।